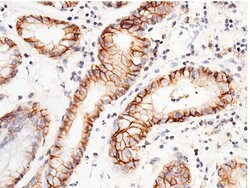
Invitrogen CD147 Recombinant Rabbit Monoclonal Antibody (125) 100 &mu;L;

Learn More
Invitrogen™ CD147 Recombinant Rabbit Monoclonal Antibody (125)


Rabbit Recombinant Monoclonal Antibody
Brand: Invitrogen™ MA529060
Description
This product is preservative free. It is recommended to add sodium azide to avoid contamination (final concentration 0.05%-0.1%). Recombinant rabbit monoclonal antibodies are produced using in vitro expression systems. The expression systems are developed by cloning in the specific antibody DNA sequences from immunoreactive rabbits. Then, individual clones are screened to select the best candidates for production. The advantages of using recombinant rabbit monoclonal antibodies include: better specificity and sensitivity, lot-to-lot consistency, animal origin-free formulations, and broader immunoreactivity to diverse targets due to larger rabbit immune repertoire. This antibody has specificity for Human CD147/Basigin/BSG.
CD147 (basigin, neurothelin, OX-47, 5A11, CE9, M6, EMMPRIN, extracellular matrix metalloproteinase inducer, TCSF, tumour cell-derived collagenase-stimulatory factor) is a 50-60 kDa glycoprotein with multiple glycosylated forms. CD147 is a plasma membrane protein that is important in spermatogenesis, embryo implantation, neural network formation, and tumor progression. CD147 is also a member of the immunoglobulin superfamily. The highest level of CD147 expression is on metabolically active cells, such as lymphoblasts, inflammatory cells, brown adipocytes and malignant tumor cells. CD147 has multiple functions, including facilitating of cell surface expression of monocarboxylate transporter proteins and extracellular matrix metalloproteinases, regulation of integrin functions, it plays roles in cell development and activation, fetal development or retinal function.
Specifications
| CD147 | |
| Recombinant Monoclonal | |
| 1 mg/mL | |
| PBS with 10% trehalose and no preservative | |
| P35613 | |
| BSG | |
| Recombinant Human CD147 protein (Met1-His205). | |
| 100 μL | |
| Primary | |
| Human | |
| Antibody | |
| IgG |
| ELISA, Flow Cytometry, Immunohistochemistry (Frozen), Immunohistochemistry (Paraffin), Western Blot, Immunocytochemistry, Western Blot | |
| 125 | |
| Unconjugated | |
| BSG | |
| 5A11; 5A11 antigen; 5A11/Basigin; 5A11/Basigin-2; 5F7; AI115436; AI325119; Basic immunoglobulin superfamily; basigin; basigin (Ok blood group); Basigin (Ox47 antigen or CE-9) (EMMPRIN in human) (neurothelin HT7 or 5A11 in avian); basignin; Basignin (Ox47 antigen or CE-9) (EMMPRIN in human) (neurothelin HT7 or 5A11 in avian); blood-brain barrier HT7 antigen; BSG; CD147; CD147 antigen; CE9; Collagenase stimulatory factor; EMMPRIN; Extracellular matrix metalloproteinase inducer; glycoprotein CE9; gp 42; gp42/basigin/OX-47/HT7; HT7; HT-7; HT7 antigen; immunoglobulin gene superfamily member; leukocyte activation antigen M6; Membrane glycoprotein gp42; neurothelin; OK; OK blood group antigen; OX-47 antigen; Ox47R; RPE7; TCSF; tumor cell-derived collagenase stimulatory factor; Unknown (protein for MGC:128392); unnamed protein product; UNQ6505/PRO21383 | |
| Rabbit | |
| Protein A | |
| RUO | |
| 682 | |
| Store at 4°C short term. For long term storage, store at -20°C, avoiding freeze/thaw cycles. | |
| Liquid |
Your input is important to us. Please complete this form to provide feedback related to the content on this product.